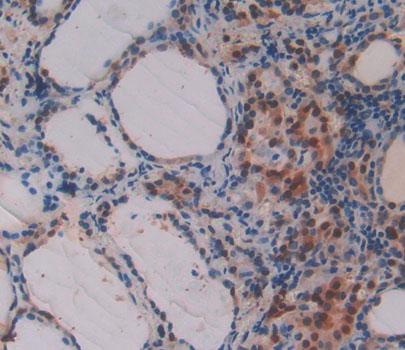
https://d1vffmuvmgkypt.cloudfront.net/image/ridacom_ltd/cloud_clone_corp/PRODUCT_SOURCE__CLOUD_CLONE__SUPPLIER__RIDACOM__ID__PAC722Hu01__1

Antigen
PDF
Reactivity
Human
(10)
Mouse
(6)
Rat
(5)
Research area
Infection immunity
(14)
Apoptosis
(12)
Cytokine
(12)
Tumor immunity
(12)
Application
Western Blotting
(14)
Immunocytochemistry
(9)
Immunohistochemistry
(9)
Immunoprecipitation
(5)
Positive Control
(5)
SDS-PAGE
(5)
Enzyme-linked immunosorbent assay for Antigen Detection
(4)
Chemiluminescent immunoassay for antigen detection
(3)
Immunofluorescence
(1)
Host
Rabbit
(5)
CHO
(3)
293F
(1)
Category
Antibodies
(9)
ELISA Kits
(7)
Cell biology
(5)
Immunochemicals
(5)
Protein Biochemistry
(5)
| 48T | $638.00 | |
| 96T | $912.00 | |
| 96T*5 | $4,104.00 |
| 96T*10 | $7,752.00 | |
| 96T*100 | $63,840.00 |
| 48T | $605.00 | |
| 96T | $864.00 | |
| 96T*5 | $3,888.00 |
| 96T*10 | $7,344.00 | |
| 96T*100 | $60,480.00 |
| 48T | $588.00 | |
| 96T | $840.00 | |
| 96T*5 | $3,780.00 |
| 96T*10 | $7,140.00 | |
| 96T*100 | $58,800.00 |
| 48T | $532.00 | |
| 96T | $760.00 | |
| 96T*5 | $3,420.00 |
| 96T*10 | $6,460.00 | |
| 96T*100 | $53,200.00 |
| 48T | $504.00 | |
| 96T | $720.00 | |
| 96T*5 | $3,240.00 |
| 96T*10 | $6,120.00 | |
| 96T*100 | $50,400.00 |
| 48T | $490.00 | |
| 96T | $700.00 | |
| 96T*5 | $3,150.00 |
| 96T*10 | $5,950.00 | |
| 96T*100 | $49,000.00 |
| 48T | $490.00 | |
| 96T | $700.00 | |
| 96T*5 | $3,150.00 |
| 96T*10 | $5,950.00 | |
| 96T*100 | $49,000.00 |

Antigen:
Growth Differentiation Factor 15
Synonyms: PDF; MIC1; NAG-1; PLAB; PTGFB; Macrophage inhibitory cytokine 1; NSAID-activated gene 1 protein; Placental bone morphogenetic protein; Prostate differentiation factor
Reactivity:Human
Application:Positive Control; SDS-PAGE; Western Blotting
Research area:Cytokine; Apoptosis; Tumor immunity; Infection immunity
Preparation method:Escherichia coli
| 10µg | $196.00 | |
| 50µg | $490.00 | |
| 200µg | $980.00 |
| 1mg | $2,940.00 | |
| 5mg | $7,350.00 |

Antigen:
Growth Differentiation Factor 15
Synonyms: PDF; MIC1; NAG-1; PLAB; PTGFB; Macrophage inhibitory cytokine 1; NSAID-activated gene 1 protein; Placental bone morphogenetic protein; Prostate differentiation factor
Reactivity:Human
Application:Positive Control; SDS-PAGE; Western Blotting
Research area:Cytokine; Apoptosis; Tumor immunity; Infection immunity
Preparation method:Escherichia coli
| 10µg | $196.00 | |
| 50µg | $490.00 | |
| 200µg | $980.00 |
| 1mg | $2,940.00 | |
| 5mg | $7,350.00 |

Antigen:
Growth Differentiation Factor 15
Synonyms: PDF; MIC1; NAG-1; PLAB; PTGFB; Macrophage inhibitory cytokine 1; NSAID-activated gene 1 protein; Placental bone morphogenetic protein; Prostate differentiation factor
Reactivity:Rat
Application:Positive Control; SDS-PAGE; Western Blotting
Research area:Cytokine; Apoptosis; Tumor immunity; Infection immunity
Preparation method:Escherichia coli
| 10µg | $194.00 | |
| 50µg | $486.00 | |
| 200µg | $972.00 |
| 1mg | $2,916.00 | |
| 5mg | $7,290.00 |

Antigen:
Reactivity:Human
Application:Positive Control; SDS-PAGE; Western Blotting
Research area:Infection immunity
Preparation method:Escherichia coli
| 10µg | $168.00 | |
| 50µg | $420.00 | |
| 200µg | $840.00 |
| 1mg | $2,520.00 | |
| 5mg | $6,300.00 |

Antigen:
Growth Differentiation Factor 15
Synonyms: PDF; MIC1; NAG-1; PLAB; PTGFB; Macrophage inhibitory cytokine 1; NSAID-activated gene 1 protein; Placental bone morphogenetic protein; Prostate differentiation factor
Reactivity:Mouse
Application:Positive Control; SDS-PAGE; Western Blotting
Research area:Cytokine; Apoptosis; Tumor immunity; Infection immunity
Preparation method:Escherichia coli
| 10µg | $152.00 | |
| 50µg | $380.00 | |
| 200µg | $760.00 |
| 1mg | $2,280.00 | |
| 5mg | $5,700.00 |

Antigen:
Growth Differentiation Factor 15
Synonyms: PDF; MIC1; NAG-1; PLAB; PTGFB; Macrophage inhibitory cytokine 1; NSAID-activated gene 1 protein; Placental bone morphogenetic protein; Prostate differentiation factor
Host:293F
Reactivity:Mouse
Application:Western Blotting; Immunohistochemistry; Immunocytochemistry; Immunofluorescence
Research area:Cytokine; Apoptosis; Tumor immunity; Infection immunity
| 20µl | $130.00 | |
| 100µl | $302.00 | |
| 200µl | $432.00 |
| 1ml | $1,080.00 | |
| 10ml | $4,320.00 |

Antigen:
Growth Differentiation Factor 15
Synonyms: PDF; MIC1; NAG-1; PLAB; PTGFB; Macrophage inhibitory cytokine 1; NSAID-activated gene 1 protein; Placental bone morphogenetic protein; Prostate differentiation factor
Host:CHO
Reactivity:Rat
Application:Western Blotting; Immunohistochemistry; Immunocytochemistry
Research area:Cytokine; Apoptosis; Tumor immunity; Infection immunity
| 20µl | $125.00 | |
| 100µl | $293.00 | |
| 200µl | $418.00 |
| 1ml | $1,045.00 | |
| 10ml | $4,180.00 |

Antigen:
Growth Differentiation Factor 15
Synonyms: PDF; MIC1; NAG-1; PLAB; PTGFB; Macrophage inhibitory cytokine 1; NSAID-activated gene 1 protein; Placental bone morphogenetic protein; Prostate differentiation factor
Host:CHO
Reactivity:Mouse
Application:Western Blotting; Immunohistochemistry; Immunocytochemistry
Research area:Cytokine; Apoptosis; Tumor immunity; Infection immunity
| 20µl | $119.00 | |
| 100µl | $277.00 | |
| 200µl | $396.00 |
| 1ml | $990.00 | |
| 10ml | $3,960.00 |

Antigen:
Growth Differentiation Factor 15
Synonyms: PDF; MIC1; NAG-1; PLAB; PTGFB; Macrophage inhibitory cytokine 1; NSAID-activated gene 1 protein; Placental bone morphogenetic protein; Prostate differentiation factor
Host:CHO
Reactivity:Human
Application:Western Blotting; Immunohistochemistry; Immunocytochemistry
Research area:Cytokine; Apoptosis; Tumor immunity; Infection immunity
| 20µl | $116.00 | |
| 100µl | $270.00 | |
| 200µl | $386.00 |
| 1ml | $965.00 | |
| 10ml | $3,860.00 |

Antigen:
Growth Differentiation Factor 15
Synonyms: PDF; MIC1; NAG-1; PLAB; PTGFB; Macrophage inhibitory cytokine 1; NSAID-activated gene 1 protein; Placental bone morphogenetic protein; Prostate differentiation factor
Host:Rabbit
Reactivity:Rat
Application:Western Blotting; Immunohistochemistry; Immunocytochemistry; Immunoprecipitation
Clonality:Polyclonal
Research area:Cytokine; Apoptosis; Tumor immunity; Infection immunity
| 20µl | $114.00 | |
| 100µl | $266.00 | |
| 200µl | $380.00 |
| 1ml | $950.00 | |
| 10ml | $3,800.00 |

Antigen:
Growth Differentiation Factor 15
Synonyms: PDF; MIC1; NAG-1; PLAB; PTGFB; Macrophage inhibitory cytokine 1; NSAID-activated gene 1 protein; Placental bone morphogenetic protein; Prostate differentiation factor
Host:Rabbit
Reactivity:Mouse
Application:Western Blotting; Immunohistochemistry; Immunocytochemistry; Immunoprecipitation
Clonality:Polyclonal
Research area:Cytokine; Apoptosis; Tumor immunity; Infection immunity
| 20µl | $108.00 | |
| 100µl | $252.00 | |
| 200µl | $360.00 |
| 1ml | $900.00 | |
| 10ml | $3,600.00 |
Antigen:
Host:Rabbit
Reactivity:Human
Application:Western Blotting; Immunohistochemistry; Immunocytochemistry; Immunoprecipitation
Clonality:Polyclonal
Research area:Infection immunity
| 20µl | $105.00 | |
| 100µl | $245.00 | |
| 200µl | $350.00 |
| 1ml | $875.00 | |
| 10ml | $3,500.00 |

Antigen:
Growth Differentiation Factor 15
Synonyms: PDF; MIC1; NAG-1; PLAB; PTGFB; Macrophage inhibitory cytokine 1; NSAID-activated gene 1 protein; Placental bone morphogenetic protein; Prostate differentiation factor
Host:Rabbit
Reactivity:Human
Application:Western Blotting; Immunohistochemistry; Immunocytochemistry; Immunoprecipitation
Clonality:Polyclonal
Research area:Cytokine; Apoptosis; Tumor immunity; Infection immunity
| 20µl | $105.00 | |
| 100µl | $245.00 | |
| 200µl | $350.00 |
| 1ml | $875.00 | |
| 10ml | $3,500.00 |

Antigen:
Growth Differentiation Factor 15
Synonyms: PDF; MIC1; NAG-1; PLAB; PTGFB; Macrophage inhibitory cytokine 1; NSAID-activated gene 1 protein; Placental bone morphogenetic protein; Prostate differentiation factor
Host:Rabbit
Reactivity:Human
Application:Western Blotting; Immunohistochemistry; Immunocytochemistry; Immunoprecipitation
Clonality:Polyclonal
Research area:Cytokine; Apoptosis; Tumor immunity; Infection immunity
| 20µl | $105.00 | |
| 100µl | $245.00 | |
| 200µl | $350.00 |
| 1ml | $875.00 | |
| 10ml | $3,500.00 |










-SCC034Hu-000001.png)



-SEC034Ra-000001.png)



-SEC034Mu-000001.png)



-SEC034Hu-000001.png)



-E92722Hu-000001.png)

-RPC034Hu01-000001.png)

-RPC034Hu02-000001.png)

-RPC034Ra01-000001.png)




-RPC034Mu01-000001.png)










-PAC034Mu01-000001.png)






-PAC034Hu01-000001.png)


-PAC034Hu02-000001.png)